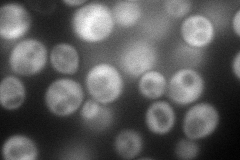
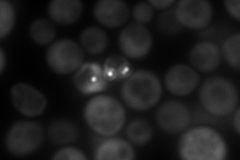
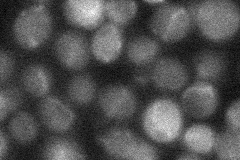
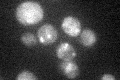

View description
Bifunctional enzyme with thiamine-phosphate pyrophosphorylase and 4-methyl-5-beta-hydroxyethylthiazole kinase activities, required for thiamine biosynthesis; GFP-fusion protein localizes to the cytoplasm in a punctate pattern
Localization:
Intensity:
Fold change:
Significance:
-
C’ GFP library in SD

below threshold15.56 -
N' NOP1pr-GFP in SD
cytosol178.552 -
N' TEF2pr-mCherry in SD
cytosol240.88 -
N' NATIVEpr-GFP in SD
cytosol22.0746 -
N' TEF2pr-VC and Cyto-VN in SD

#N/A0 -
C’ GFP library in SD+DTT

cytosol22.641.45No -
C’ GFP library in SD+H2O2

cytosol14.640.94No -
C’ GFP library in Starvation Media
cytosol28.291.81No -
C’ GFP library on the background of Pup2-DaMP

below threshold -
C’ GFP library on the background of CCT mutant

below threshold20.34811.30694No
